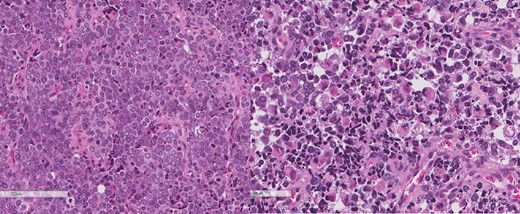
The intrathoracic tumor shows similar morphology to the sarcomatous component of the esophageal tumor, with focal rhabdomyoblastic differentiation.

-
PDF
- Split View
-
Views
-
Cite
Cite
Mohammad Alamassi, Esraa Yaseen Arabi, Haitham Arabi, Waleed Saleh, A rare case of carcino-sarcoma of the esophagus with huge intrathoracic metastasis, Journal of Surgical Case Reports, Volume 2024, Issue 4, April 2024, rjae236, https://doi.org/10.1093/jscr/rjae236
Close - Share Icon Share
Abstract
Carcinosarcoma of the esophagus constitutes only 0.5%–2.8% of all malignant esophageal cancers. It is identified by the presence of both carcinomatous and sarcomatous components. A clear regimen of treatment has not been established due to the limited understanding of the disease. We present a case of carcinosarcoma of the esophagus with rapid recurrence and invasion to the intrathoracic cavity only 6 weeks after esophagectomy. Carcinosarcoma carries a poor prognosis, as it has a late tendency of hematogenous spread with a high growth rate.
Introduction
Carcino-sarcoma of the esophagus is a rare malignant tumor that compromises 0.2%–2.3% of all esophageal neoplasms [1]. Such cancers consist of carcinomatous and sarcomatous components with polypoidal pattern of growth and limited deep invasion to adjacent organs. Treatment follows the same principles of any esophageal cancers with a poor documented prognosis [2, 3]. We present a case of carcinosarcoma of the esophagus with rapid recurrence and invasion to the intrathoracic cavity only 6 weeks after esophagectomy.
Case presentation
This is a 65-year-old male who was diagnosed with poorly differentiated adenocarcinoma of the esophagus in an outside hospital 4 months prior to his presentation. Endoscopy done previously showed lower esophageal fungating mass that was partially obstructing the lumen. Biopsies taken showed adenocarcinoma. Patient staging work up was negative for metastasis. He received neo-adjuvant chemotherapy and underwent esophagectomy with gastric pull-up 6 weeks before his presentation. He presented to our hospital with a history of progressive shortness of breath, fever, fatigue, loss of appetite, cough, dysphagia, and voice hoarseness. Upon examination, there was a decreased air entry on the right side of the chest with right lung opacity seen on chest X-ray (Fig. 1). CT chest scan showed right posterior mediastinal heterogeneous mass, suggestive of hematoma with pleural thickening (Fig. 2). The patient was booked for right video-assisted thoracoscopic surgery. During the procedure, a right lesion occupying the whole right hemithorax was identified with multiple chest wall nodules, and all were biopsied. After the operation, the patient developed septic shock and eventually went into renal failure, respiratory failure, and cardiac arrest. Patient deceased 24 days after admission.


CT scan of the chest showing right large posterior mediastinal heterogeneous soft tissue mass.
A review of the previously resected esophageal tumor revealed the presence of both epithelial and sarcomatous components. The epithelial component was composed of moderately to poorly differentiated adenocarcinoma, while the sarcomatous component showed hyperchromatic round to spindle cells with scant cytoplasm and frequent mitoses (Figs 3–6). The intrathoracic tumor showed a similar morphology as the sarcomatous component of the esophageal tumor, with focal rhabdomyoblastic differentiation (Fig. 7). The latter was strongly positive for desmin, myogenin, and MyoD1 and was focally positive for synoplastin, CD56, CD 10, and FL1.

Low power magnification of the esophageal tumor exhibiting the epithelial (left) and the sarcomatous components (right).

High power magnification of the esophageal tumor showing the adenocarcinoma intermixed with spindle cell sarcoma.

The epithelial component of the esophageal tumor is composed of moderately to poorly differentiated adenocarcinoma.

The sarcomatous component of the esophageal tumor is formed of hyperchromatic round to spindle cells with scant cytoplasm and frequent mitoses.
The intrathoracic tumor shows similar morphology to the sarcomatous component of the esophageal tumor, with focal rhabdomyoblastic differentiation.
Discussion
Esophageal cancer is ranked to be the sixth most common cancer worldwide and the third most common gastrointestinal cancer [3, 4]. Carcinosarcoma constitutes only 0.5%–2.8% of all malignant esophageal cancers, which makes it a rare subtype [5]. Carcinosarcoma is identified by the presence of both carcinomatous and sarcomatous components [5]. To diagnose carcinosarcoma, it is essential to have a microscopic findings of the transitional zone, a sarcomatous component, or the two combined, which can also be supported by immuno-histochemical markers [6]. We do hypothesize that the endoscopy samples of this patient were taken from the carcinomatous component missing the sarcomatous component and leading to the initial diagnosis of adenocarcinoma.
The initial presentations of carcinosarcoma and squamous cell carcinoma of the esophagus are similar [5]. Patients commonly present with dysphagia that may be accompanied with chest pain and weight loss [5]. Smoking, alcohol drinking, history of squamous cell carcinoma, and middle-aged and elderly men are at risk of developing carcinosarcoma [2]. Grossly carcinosarcoma can be classified as ploypoid type (75%) or ulcerative type (15%), depending on the composition of the tumor [5]. In most cases, the sarcomatous component dominates, resulting in a ploypoid type with scant stromal cells, whereas the ulcerative type is seen when the carcinomatous component dominates [5]. The majority of esophageal carcinosarcomas (ECSs; 80%) are found in the middle and/or lower esophagus and are characterized by an intraluminal growth with limited invasion to adjacent structures, leading to earlier development of symptoms [2, 5]. On the contrary, the rate of lymph node metastasis of ECS is comparable to that of esophageal squamous cell carcinoma (ESCC; 50%–67%), while the rate of the hematogenic ECS spread is higher [5].The treatment of carcinosarcoma follows the same principles of other esophageal tumors [7]. Total or partial surgical esophagectomy with wide lymph node dissection must be considered in all patients who can tolerate surgery [8, 9]. The use of cocomintant neo-adjuvant/adjuvant chemotherapy, radiotherapy, and chemo-radiotherapy has been reported to reduce the bulk of the tumor and eliminate any residual disease [8]. In a review of 57 cases of ECSs, 54 patients underwent surgical resection [6]. Of the latter, eight underwent chemotherapy, six underwent chemoradiotherapy, and one underwent radiotherapy [6]. After 12 months of surgery, 8 out of 47 patients died of disease recurrence and 11 were lost to follow-up [6]. The recurrence was found locally (n = 5), to the lymph nodes (n = 3), to the liver (n = 2), to the lungs (n = 3), to the brain (n = 2), and to the peritoneum (n = 2) [6]. A clear regimen of carcinosarcoma treatment has not been established due to the scarcity of cases and limited understanding of the disease.
The prognosis of carcinosarcoma is controversial. Some state that the nature of intraluminal growth of the tumor leads to early detection and thus a better prognosis [7]. In addition, its invasion to other organs is less when compared to that of squamous cell carcinoma, making it more resectable even in advanced stages [7]. Although carcinosarcoma showed a better 3-year survival rate when compared to that of squamous cell carcinoma, there was no difference in the 5-year survival rate between both [9]. This ought to the fact that carcinosarcoma has a late tendency of hematogenous spread [5]. It is also documented that ECS doubling time was 2.2 months, while ESCC doubling time was 5 months [5]. Moreover, the sarcomatous component tends to be more resistant to chemotherapy and/or radiotherapy, which contributes to a worse prognosis [7]. We do hypothesize that the fast metastasis of esophageal tumor to the thoracic cavity in our case was by hematogenous spread that lead to a poor prognosis.
Author contributions
All authors contributed to the case report and manuscript writing.
Conflict of interest statement
None declared.
Funding
None declared.